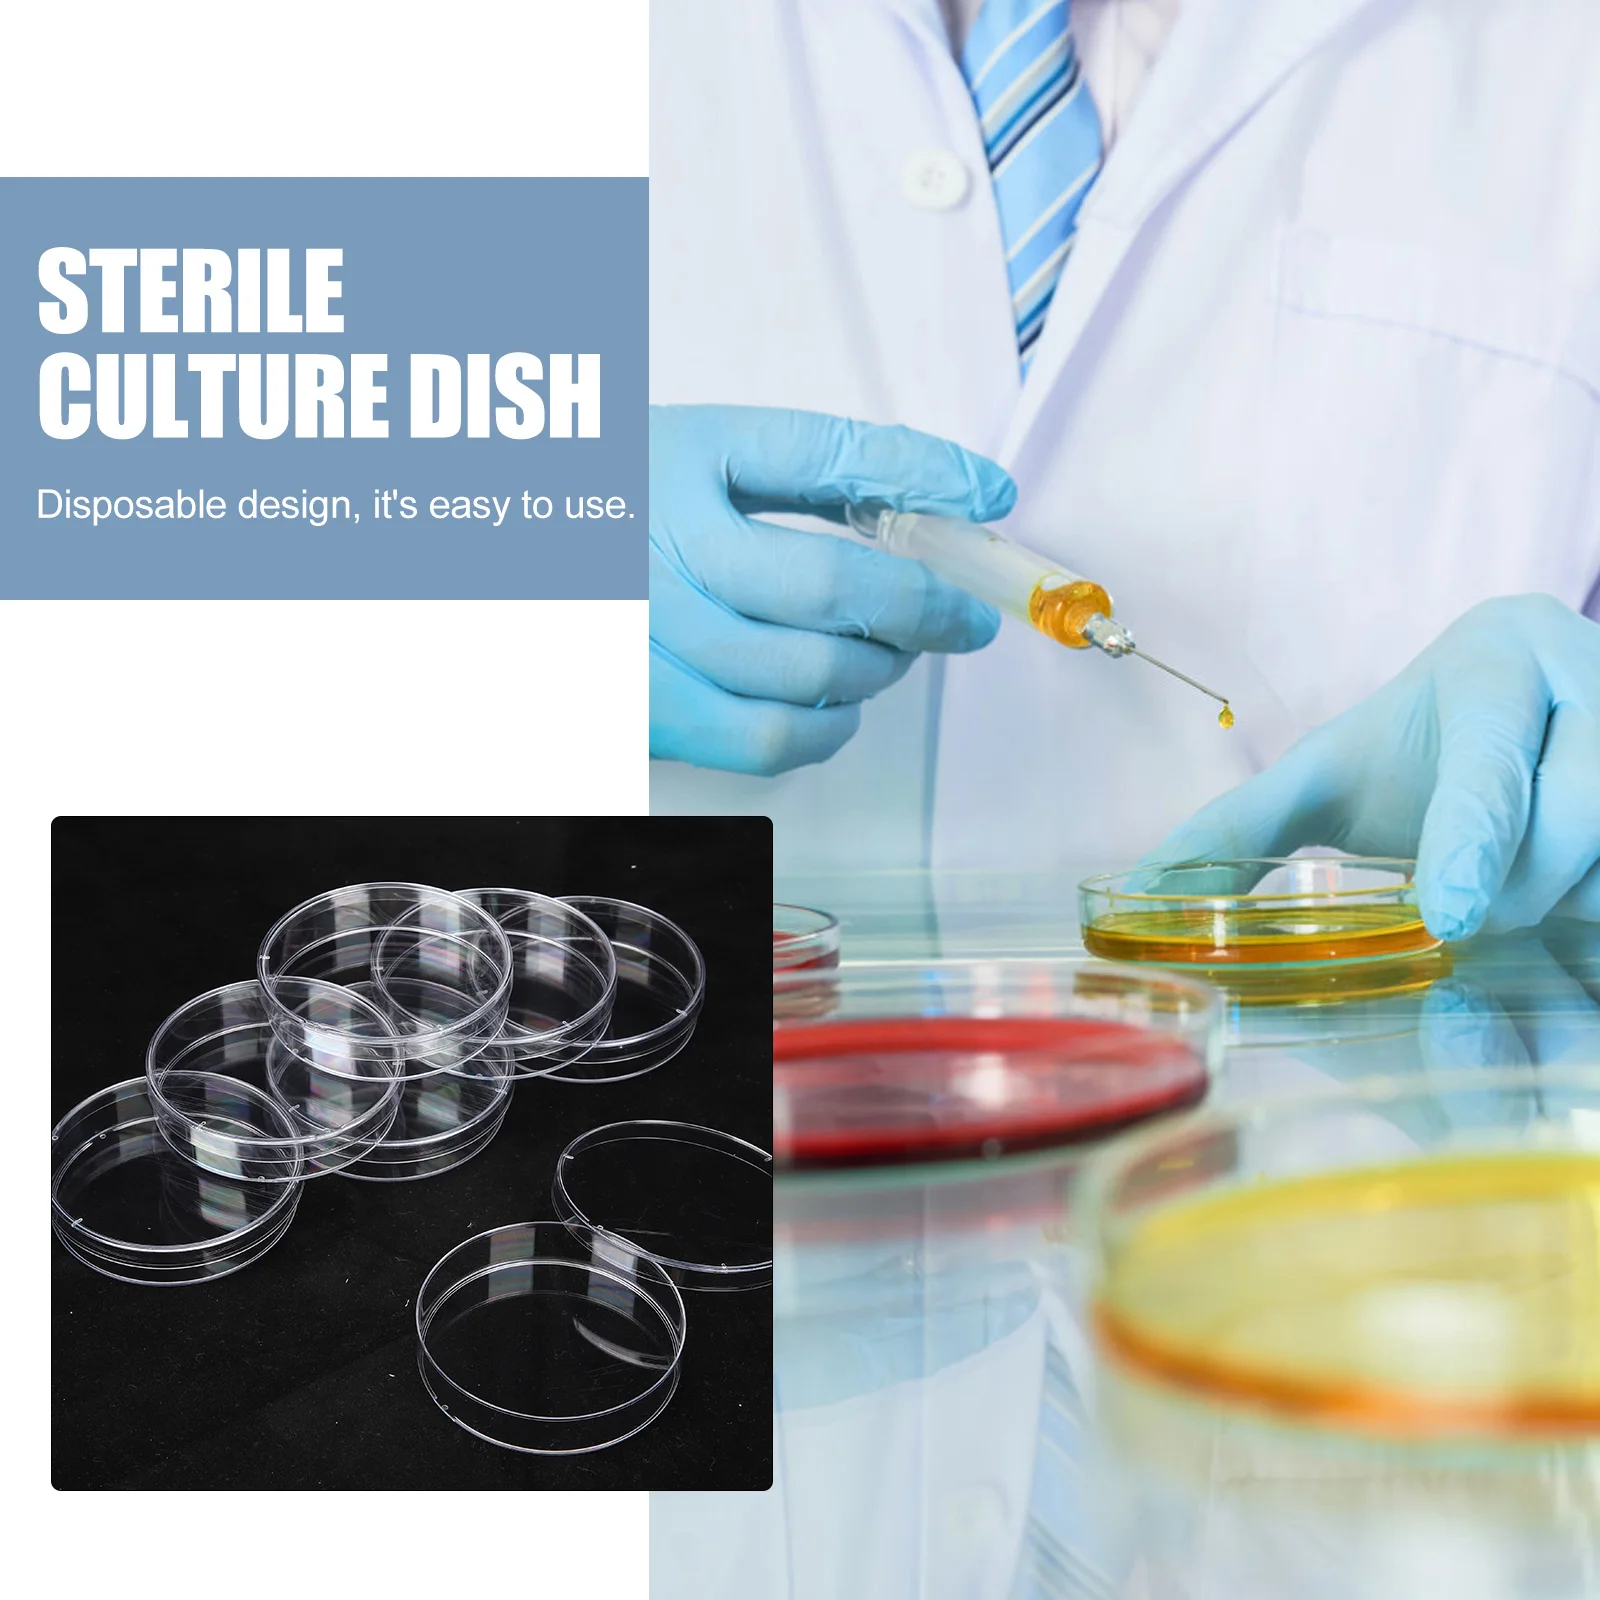
thumb

Тарелка Петри для культивирования, тарелки с крышками, тарелки для агаров, лабораторные принадлежности, стекло
Price history chart & currency exchange rate
Customers also viewed

$127.47
VEVOR Poussoir à Saucisses Machine à Saucisse 3L Remplissage de Saucisse horizontal de saucisse remplissante de saucisse en acier inoxydable
vevor.com
$3.67
Bike Bolt M5*17mm M5x19mm Titanium Bolt with Nut for Bicycle Stem Front Fork Fixing MTB Road Bike Handlebar Stem Rear Lock Screw
aliexpress.com
$24.99
Women's Shirt Blouse Polyester Ribbed Buttons Casual Fashion Long Sleeve V Neck White Spring & Fall
lightinthebox.com
$53.05
handgemaakte kralen luxe vrouwen clutch bag celebrity avondfeest handtas portemonnee diamond shiny tote prom purse 220509
dhgate.com
$28.85
luxury copper bead letter lock necklace female multilayer clavicle chain female accessories social gift, Black
dhgate.com
$92.52
designer bags cross body bag handbags crossbody handbag totes barrel-shaped leather high-capacity evening party shopping occasions
dhgate.com
$26.47
children's outdoor summer sandals letters soft baby boys and girls non-slip toddler shoes slippers soft sole walking shoes fo299z, Black;red
dhgate.com
$31.35
designer yoga sportwear tracksuits fitness 2 piece set bra long pants leggings two piece set workout clothes sports gym cloth258q, Gray
dhgate.com
$31.19
luxury designer wallet damier coin purse zippy lady chain wallets fold card holder passport women flower purses key pouch shi227b, Red;black
dhgate.com
$239.58
benro tr227c tr227 portable tripod carbon fiber camera tripods slr stands 3 section max loading 8kg
dhgate.com
$42.32
shorts summer arts style women back lacing loose shirt casual solid cotton linen turn-down collar vintage blouses femme m233 21dg, White;black
dhgate.com
$43.50
electric cat toys pet toy intelligence trainning interactive kitten roller tracks with colorful butterfly
dhgate.com
$44.50
sandals 2021 summer rhinestone all-match flat pointed bow bridal wedding shoes banquet dress women, Black
dhgate.com
$14.18
women t shirt summer casual tshirts tees harajuku colorful love heart new kawaii short sleeve female t shirt, White
dhgate.com
$41.58
matching couple clothing autumn winter long sleeves 100% cotton men women pajamas set lapel plaid home suit sleepwear nightwear, Blue;gray
dhgate.com
$13.15
boys' 2021 new spring and autumn baby's pajamas summer home children's thin long sleeve air-conditioned clothes, Blue;red
dhgate.com
$26.22
Soft & Dri Aluminum Free Sweet Bliss Deodorant 2.3oz Deodorant Roll-on - For Women(68 ml)
flipkart.com
$11.32
Snoogg Eco Friendly Canvas Black And White Pattern Designer Backpack Rucksack School Travel Unisex Casual Canvas Bag Bookbag Satchel 5 L Backpack(Blue)
flipkart.com